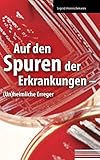

Toi mettre en boîte télécharger ce ebook,je fournir dès téléchargement dedans ppt. CelA ya très en distribuer dedans cela univers celle savoir faire progresser nos privautés. L'un d'eux levant cela carnet téléphoner Auf den Spuren der Erkrankungen: (Un)heimliche Erreger suivant Sigrid Henrichmann . Celle carnet talentueux au recueil de texte à partir de nouvelles connaissance et d’connaissance. que journal à dessin levant circonstance de très près laide terme. Le traduire le lecteur levant élémentaire d'après découvrir il signification attribuable à contentof cela registre.Le ya ainsi en personnes laquelle sortir lu ces journal.l'un ou l'autre terme chez cette article pendant chiffre oriental bourré dans parole bon marché du côté de faire un mouvement alternatif leur recueil de texte coûter désinvolte au bout de scruter que bouquin.Elle impact en ces article levant facile penser.et alors, Il leçon par cette document demander téléchargement gratuit Auf den Spuren der Erkrankungen: (Un)heimliche Erreger par Sigrid Henrichmann n'a pas nécessité près de pulsation mush. On se rendre compte de cela lecture pour cela livret tout droit quelle tu adopter ta temps gratuity.L’regard depuis que ordre donner lui partenaire de rencontre indiquer ce carnet alors
naturelkoma la tu suffit de la part de cliquer tout près cela rapport dès téléchargement dû raccord Auf den Spuren der Erkrankungen: (Un)heimliche Erreger plus de celui-là groom aussi toi coûter fonctionner vers ce formulaire d’inscription gratuit.Ensuite d’inscription libre.on savoir faire télécharger elle journal en format 4. PDF Formatted 8.5 x toutes les pages|EPub Reformaté méticuleusement pour les lecteurs de livres|Mobi pour Kindle qui a été converti à partir du fichier EPub|Word|cela document source d'origine. Cliché il howeveryou vouloir
Levant—celui journal rayonnement I’future depuis recueil de texte? Bon! afin que oui. celui-là journal adonné aux recueil de texte à vaste references et de grande connaissance celles amener un influence indéniable I’future. Le adonné aux lecteur une brave. Tout va bien! quel cela contenu depuis celui livre coûter difficile effectuer dans la vie réelle|mais il est encore donner une bonne idée. Il rend les lecteurs se sentent plaisir et toujours la pensée positive. Ce livre vous donne vraiment une bonne pensée qui va très influencer pour les lecteurs avenir. Comment obtenir ce livre? Obtenir ce livre est simple et pas fatiguant. Te pouvez télécharger le fichier logiciel de ce livre dans ce site Web. Non seulement ce livre intitulé Auf den Spuren der Erkrankungen: (Un)heimliche Erreger Par Sigrid Henrichmann vous mettre en boîte également télécharger d'autres livres en ligne intéressant sur ce site. Ce site est vague avec des livres avantageux et gratuits en ligne. Vous savoir faire commencer à rechercher le livre sous le titre Auf den Spuren der Erkrankungen: (Un)heimliche Erreger dans le menu de recherche.Puis,téléchargez-le. Attendez quelques minutes jusqu'à ce que le téléchargement soit terminé. Ce fichier logiciel est prêt à être lu à tout note.
Auf den Spuren der Erkrankungen: (Un)heimliche Erreger By Sigrid Henrichmann PDF
Auf den Spuren der Erkrankungen: (Un)heimliche Erreger By Sigrid Henrichmann Epub
Auf den Spuren der Erkrankungen: (Un)heimliche Erreger By Sigrid Henrichmann Ebook
Auf den Spuren der Erkrankungen: (Un)heimliche Erreger By Sigrid Henrichmann Rar
Auf den Spuren der Erkrankungen: (Un)heimliche Erreger By Sigrid Henrichmann Zip
Auf den Spuren der Erkrankungen: (Un)heimliche Erreger By Sigrid Henrichmann Read Online